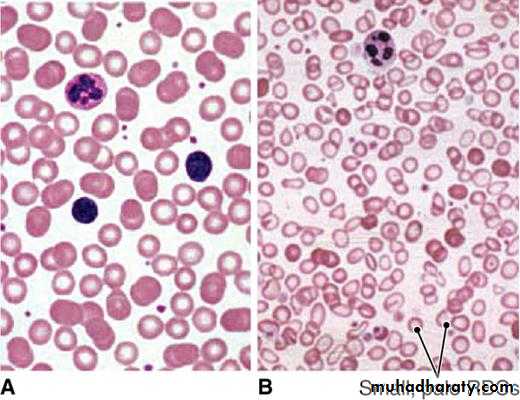

Dr.Fakhir Yousif
General physical examinationHow to inspect
Make sure the room is in a comfortable temperatureUse good lighting, preferably sunlight
Look and observe before touching
Completely expose the body part you are inspecting while draping the rest
Compare symmetrical body parts
Important aspects of physical examination
• Where does the examiner stand?Exam with your right hand
Inspection
• Method of observation used during physical examination• First step in examining a patient or body part
• It includes a general survey of the patient’s
• mental status posture
• body movement gait
• breath odor skin
• speech stature
• state of nutrition
Obese or wasted ?
face
Handslegs
anemia
Pallor and anemia
pa;
Iron deficiency anemia
Pernicous anemia
Shaved tongueLoss of papillae
Pale hands
palmar crease
Compare the color of the palm
Look at the palmar crease
koilonychia
jaundice
Flapping tremor
CentralCyanosis
Peripheral cyanosis
Cyanosisclubbing
Fingers & toes clubbing
psoriasis
Lymphadenopathy
Infection
Lymphoproliferative diseaseleukemia
causes
Heart failureLiver failure
Nephrotic syndrome
Bleeding signs
Petechiae
Purpuraechymoses